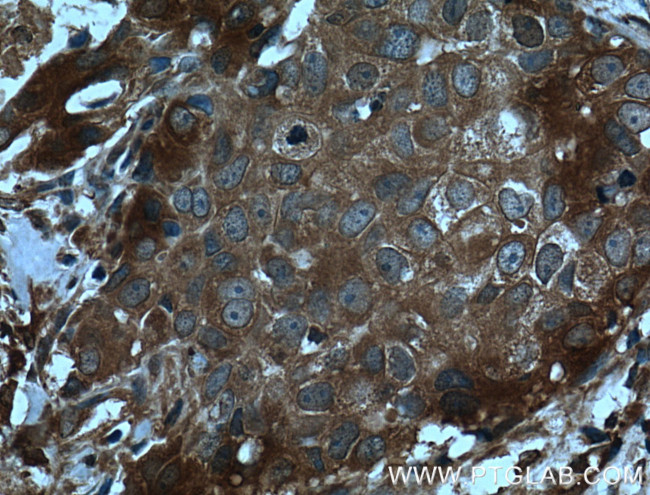
CCL24/Eotaxin 2 Antibody in Immunohistochemistry (Paraffin) (IHC (P))

Search
Proteintech
CCL24/Eotaxin 2 Polyclonal Antibody
{{$productOrderCtrl.translations['antibody.pdp.commerceCard.promotion.promotions']}}
{{$productOrderCtrl.translations['antibody.pdp.commerceCard.promotion.viewpromo']}}
{{$productOrderCtrl.translations['antibody.pdp.commerceCard.promotion.promocode']}}: {{promo.promoCode}} {{promo.promoTitle}} {{promo.promoDescription}}. {{$productOrderCtrl.translations['antibody.pdp.commerceCard.promotion.learnmore']}}
产品信息
22306-1-AP
种属反应
宿主/亚型
分类
类型
抗原
偶联物
形式
浓度
纯化类型
保存液
内含物
保存条件
运输条件
靶标信息
Eotaxin 2 belongs to the subfamily of small cytokine CC genes. Cytokines are a family of secreted proteins involved in immunoregulatory and inflammatory processes. The CC cytokines are proteins characterized by two adjacent cysteines. The cytokine encoded by this gene displays chemotactic activity on resting T lymphocytes, a minimal activity on neutrophils, and is negative on monocytes and activated T lymphocytes. The protein is also a strong suppressor of colony formation by a multipotential hematopoietic progenitor cell line.
仅用于科研。不用于诊断过程。未经明确授权不得转售。
生物信息学
蛋白别名: C-C motif chemokine 24; CC chemokine CCL24; chemokine (C-C motif) ligand 24; CK-beta-6; Eosinophil chemotactic protein 2; Eotaxin-2; Eotaxin2; MPIF-2; Myeloid progenitor inhibitory factor 2; small inducible cytokine A24; small inducible cytokine subfamily A (Cys-Cys), member 24; Small-inducible cytokine A24
基因别名: CCL24; CKb-6; MPIF-2; MPIF2; SCYA24
UniProt ID: (Human) O00175, (Mouse) Q9JKC0
Entrez Gene ID: (Human) 6369, (Mouse) 56221